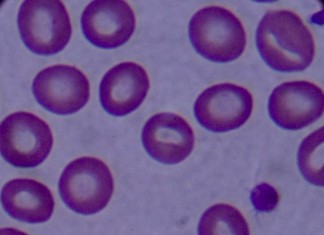
Ученые вновь маркируют рак

Обнаружен способ попадания коронавирусов в организм человека
Высокотехнологичные криоэлектронные микроскопы и компьютерный продвинутый анализ моделирования являются самыми полезным...
Пример летучей мыши подтолкнул ученых к истреблению вирусов
Если бы летучие мыши были бы также подвержены вирусам, как люди Эболе, то слепота была бы меньшей из проблем, если бы бы...
Определена связь между миграцией и нейронными связями у птиц
Птицы, преодолевающие более значительные расстояния в процесс миграции, обладают большим количеством нейронных связей и...
Найдена связь между нетерпением и ускоренным старением
Смешанная группа исследователей из США и Сингапура вынесла достаточно интересный и необычный тест на то, каким образом н...
Ученые на шаг приблизились к созданию супер-компьютера
Команда международных исследователей обнаружила способ позволяющий регулировать состояние электронов, со спокойного в во...
Действительно ли Земля является уникальной планетой?
В известной нам Вселенной существует около 700 триллионов планет и звезд, причем достаточно долгое время считалось, что ...
Ученые возвращают конденсаторы в электронику
Аккумуляторы становятся все лучше, надежнее, продуктивнее, но их КПД не повышается выше 90%, плюс к тому они вырабатываю...
Ученые вновь маркируют рак
Рак головы и шеи находится на шестом месте по распространенности, однако, несмотря на такую популярность, биомаркеры для...
Рачок-богомол вдохновил создание новых поляризаторов
Изучая механизмы связи с внешним миром у креветки-богомола, ученые из Университета Бристоль в Великобритании, обнаружили...
Ученые нашли ген восстанавливающий связи в мозге
Аутизм вызывает все больше тревог у докторов и ученых, за 40 лет эта болезнь приобрела огромные масштабы увеличив случаи...